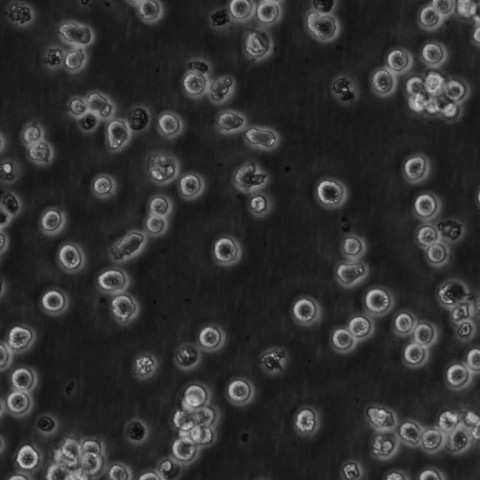
CCRF.CEM Cells人急性淋巴细胞白血病T淋巴可传代细胞系(送STR鉴定图谱)

"CCRF.CEM Cells人急性淋巴细胞白血病T淋巴可传代细胞系(送STR鉴定图谱)
形态特性:淋巴母细胞样
生长特性:悬浮生长
背景信息:G.E. Foley 等人建立了类淋巴母细胞细胞株CCRF-M。 细胞是1964年11月从一位四岁白人女性急性淋巴细胞白血病患者的外周血白血球衣中得到。此细胞系从香港收集而来。
CCRF.CEM Cells人急性淋巴细胞白血病T淋巴可传代细胞系(送STR鉴定图谱)
┈订┈购(技术服务)┈热┈线:1┈3┈6┈4┈1┈9┈3┈0┈7┈9┈1【微信同号】┈Q┈Q:3┈1┈8┈0┈8┈0┈7┈3┈2┈4;
GM13113 Cells(提供STR鉴定图谱)
HAP1 FAT1 (-) 1 Cells(提供STR鉴定图谱)
细胞培养基应用选择:选择培养基没有一定的标准,有几点建议可供参考:(1)建立某种细胞株所用的培养基应该是培养这种细胞的培养基。可以查阅参考文献,或在购买细胞株时咨询。(2)其它实验室惯用的培养基不妨一试,许多培养基可以适合多种细胞。(3)根据细胞株的点、实验的需要来选择培养基。如小鼠细胞株多选 RPMI1640。(4)用多种培养基培养目的细胞,观察其生长状态,可以用生长曲线、集落形成率等指标判断,根据实验结果选择Zui佳培养基,这是Zui客观的方法,但比较繁琐。以下是部分细胞常用的培养条件:293人胚胎肾细胞培养条件:MEM,10%热灭活马血清;IMR-90人肺成纤维细胞培养条件:MEM,10%胎牛血清和NEAA;W1-38人胚胎肺成纤维细胞培养条件:MEM,10%胎牛血清;A549人肺癌上皮细胞培养条件:F-12K,10%胎牛血清;A431人表皮癌细胞培养条件:DMEM,10%胎牛血清;BHL-100人乳房上皮细胞培养条件:McCoy'5A, 10%胎牛血清;BeWo人绒毛癌上皮滋养层细胞培养条件:F-12K,15%胎牛血清;Caco-2人结肠腺癌上皮细胞培养条件:MEM,10%胎牛血清和NEAA;Chang人肝脏上皮细胞培养条件:BME,10%小牛血清;HC-15人结肠直肠腺癌上皮细胞培养条件:RPMI-1640,10%胎牛血清;HEp-G2人肝细胞癌上皮细胞培养条件:MEM,10% 胎牛血清和NEAA;HEp-2人喉癌上皮细胞培养条件:MEM,10% 胎牛血清;或RPMI-1640,10%胎牛血清;H-29人结肠腺癌上皮细胞培养条件:McCoy'5A,10%胎牛血清;JEG-2人绒毛膜癌上皮细胞培养条件:MEM,10%胎牛血清;KB人口腔癌上皮细胞培养条件:MEM,10%胎牛血清和NEAA;Saos-2人骨肉瘤上皮细胞培养条件:McCoy'5A,15%胎牛血清;WI-38人胚胎肺上皮细胞培养条件:BME,10%胎牛血清;WISH人羊膜上皮细胞培养条件:BME, 10%胎牛血清;HUVEC人脐带内皮细胞培养条件:F-12K,10%胎牛血清和肝素100ug/ml;IM-9人骨髓瘤成淋巴细胞培养条件:RPMI-1640,10%胎牛血清;Daudi人淋巴瘤细胞培养条件:RPMI-1640,10%胎牛血清;Clone M-3小鼠黑素瘤上皮细胞培养条件:F-10,15%马血清和2.5%胎牛血清;BHK-21仓鼠肾成纤维细胞培养条件:GMEM,10%胎牛血清或MEM,10%胎牛血清和NEAA;CHO-K1仓鼠卵巢上皮细胞培养条件:F-12,10%胎牛血清;IEC-6大鼠正常小肠上皮样培养条件:DMEM,5%胎牛血清,胰岛素0.1μg/ml;COS-1猴肾成纤维细胞培养条件:MEM,10%胎牛血清;COS-3猴肾成纤维细胞培养条件:MEM,10%胎牛血清;COS-7猴非洲绿猴肾成纤维细胞培养条件:MEM,10%胎牛血清
HAP1 ZDHHC24 (-) 1 Cells(提供STR鉴定图谱)
HL-60-Y3 Cells(提供STR鉴定图谱)
换液周期:每周2-3次
公司细胞系主要引进ATCC、DSMZ、JCRB、KCLB、RIKEN、ECACC等细胞库,细胞系体外培养,它们会成长为单层细胞,附着或紧贴在培养瓶上,或悬浮在体外的溶液中,细胞系复苏周期短,公司细胞系状态良好,饱满,有光泽等优点。EDTA的作用:许多人不用胰酶,只用EDTA,或者用胰酶/EDTA联合作用。这里要明白,胰酶切割细胞外基质的一些负责粘连和附着的蛋白,而EDTA通过螯合Ca离子,作用于整联蛋白的活性,所以EDTA的作用更加温和。有的人在胰酶里添加一些EDTA,或者对付特别难消化的细胞,添加多一些EDTA,就是这个道理。一般不要试图延长消化时间(如果10min还消化不下来的话),而应该想其它办法。
传代比例:1:2-1:4(首次传代建议1:2)
产品包装:复苏发货:T25培养瓶(一瓶)或冻存发货:1ml冻存管(两支)
CCRF.CEM Cells人急性淋巴细胞白血病T淋巴可传代细胞系(送STR鉴定图谱)
┈订┈购(技术服务)┈热┈线:1┈3┈6┈4┈1┈9┈3┈0┈7┈9┈1【微信同号】┈Q┈Q:3┈1┈8┈0┈8┈0┈7┈3┈2┈4;
来源说明:细胞主要来源ATCC、ECACC、DSMZ、RIKEN等细胞库
iPSC DKC1 Q31E Cells(提供STR鉴定图谱)
MCCL-2 Cells(提供STR鉴定图谱)
ND12023 Cells(提供STR鉴定图谱)
PNUi004-C Cells(提供STR鉴定图谱)
Shi/FeT-1C Cells(提供STR鉴定图谱)
物种来源:人源、鼠源等其它物种来源
有一些细胞是数量多一点比较HAO生长,生长状态也比较HAO。这种一般是属于生长速度慢的细胞。譬如内皮细胞。而有一些是细胞是数量少一点细胞状态会生长的比较HAO,譬如巨噬细胞和某些肿瘤细胞。尤其是巨噬细胞,生长速度非常得快,贴壁速度很快,所以传代时就应该留很少量的细胞,这样细胞状态会比较HAO。并且巨噬细胞比较喜欢扎堆生长,而堆与堆之间是有空间的。如果长成相连在一起的一满片的时候,细胞形态基本上就会差了,老化的会比较多,对后期实验结果是不HAO的。所以在养细胞的时候应该摸索该细胞喜欢的生长空间密度问题。这个其实是有一个方法可以改善的。对于贴壁细胞,如果细胞形态不HAO,(或者细胞形态不清晰,表面似有异物等)可以在传代的时候进行如下操作:首先,倒掉旧的培养基,加入3ml新的培养基(有无血清的都可)洗涤一次,用滴管吸走,然后再加入3ml的培养基,进行预吹打,控制吹打力度,轻轻地大概沿着瓶底过一遍,然后吸走。这时侯再开始正式的消化、吹打。(巨噬细胞建议只吹打,不消化)其次,把吹打下来的细胞悬加入到新的培养瓶内,培养瓶事先加入培养基,放入培养箱内培养,按时间点观察细胞贴壁情况。10分钟观察一次,20分钟,30分钟观察一次。选择一个时间点,已经有部分细胞贴壁的情况下,重新置于洁净台,底面朝上迅速倒出其中的培养基,加入3ml新培养基再轻轻洗一次。然后加入完全培养基培养。后续观察细胞生长情况以及形态。通常称之为“二传”。如果一次效果还不理想,可重复多次。直到找到细胞上乘形态。其中要注意,结合细胞喜欢的生长情况。喜欢多一点数量长得HAO的细胞你就等贴壁细胞比较多点的时候再传。反之亦然。
4f1-1 Cells(提供STR鉴定图谱)
Abcam K-562 ALDH4A1 KO Cells(提供STR鉴定图谱)
AmphoPack-293 Cells(提供STR鉴定图谱)
BayGenomics ES cell line RRK249 Cells(提供STR鉴定图谱)
BayGenomics ES cell line XL954 Cells(提供STR鉴定图谱)
CAL-44 Cells(提供STR鉴定图谱)
DA00586 Cells(提供STR鉴定图谱)
DA06111 Cells(提供STR鉴定图谱)
GM00604 Cells(提供STR鉴定图谱)
Human Epidermoid carcinoma #2 Cells;背景说明:最初认为这个细胞源自喉上皮癌,但随后通过同功酶分析、HeLa标记染色体和DNA指纹分析发现,起源细胞已被HeLa污染。 角蛋白免疫过氧化物酶染色阳性。;传代方法:1:2传代;生长特性:贴壁生长;形态特性:上皮细胞样;相关产品有:HCC1569细胞、NBL-4细胞、NS20Y细胞
A375-S2 Cells;背景说明:详见相关文献介绍;传代方法:1:2传代;生长特性:贴壁生长;形态特性:上皮样;相关产品有:Roswell Park Memorial Institute 7666细胞、SU-DHL-16细胞、C8166细胞
NCI-H1435 Cells;背景说明:详见相关文献介绍;传代方法:1:3-1:6传代,每周换液2-3次;生长特性:贴壁生长,松散;形态特性:详见产品说明书;相关产品有:Rat-1细胞、MHCC97L细胞、NCI-H1668细胞
KYSE140 Cells;背景说明:食管鳞癌细胞;男性;传代方法:1:2-1:3传代;每周换液2-3次。;生长特性:贴壁;形态特性:详见产品说明书;相关产品有:H1573细胞、BJ1细胞、H1299细胞
28SC Cells;背景说明:急性单核细胞白血病;男性;传代方法:1:2-1:3传代;每周换液2-3次。;生长特性:悬浮;形态特性:详见产品说明书;相关产品有:CCC-ESF-1细胞、HEC1A细胞、COLO201细胞
3T3-442A Cells;背景说明:脂肪前体细胞;雄性;Swiss albino;传代方法:1:2-1:3传代;每周换液2-3次。;生长特性:贴壁;形态特性:详见产品说明书;相关产品有:SK-MEL-MeWo细胞、PANC 327细胞、RKO-AS45-1细胞
TFK1 Cells;背景说明:胆管癌;男性;传代方法:1:2-1:3传代;每周换液2-3次。;生长特性:贴壁;形态特性:详见产品说明书;相关产品有:ID8细胞、H520细胞、HCC1143细胞
Sup T-1 Cells;背景说明:详见相关文献介绍;传代方法:2-3天换液1次。;生长特性:悬浮生长;形态特性:淋巴母细胞样 ;相关产品有:NTERA-2 cl.D1细胞、MC116细胞、SK-MEL-MeWo细胞
SUDHL4 Cells;背景说明:详见相关文献介绍;传代方法:1:2-1:3传代;每周换液2-3次。;生长特性:悬浮;形态特性:淋巴母细胞;相关产品有:3T3-Swiss albino细胞、MPC-11细胞、GM0637细胞
OUMS-23 Cells;背景说明:详见相关文献介绍;传代方法:1:2-1:3传代;每周换液2-3次。;生长特性:贴壁或悬浮,详见产品说明书部分;形态特性:详见产品说明书;相关产品有:210RCY3-Ag1.2.3细胞、SF 763细胞、COLO206F细胞
HRGEC Cells;背景说明:肾小球;内皮 Cells;传代方法:1:2-1:3传代;每周换液2-3次。;生长特性:贴壁;形态特性:详见产品说明书;相关产品有:OCI-LY-18细胞、HTR8svn细胞、RERF-LCMS细胞
EVSA/T Cells;背景说明:乳腺癌;腹水转移;女性;传代方法:1:2-1:3传代;每周换液2-3次。;生长特性:贴壁;形态特性:详见产品说明书;相关产品有:OCI/AML-5细胞、NCI-H196细胞、A9细胞
S-16 Cells;背景说明:Schwann细胞;自发永生;传代方法:1:2-1:3传代;每周换液2-3次。;生长特性:贴壁;形态特性:详见产品说明书;相关产品有:Hs578Bst细胞、Vero 76 clone E-6细胞、QGY 7701细胞
Normal fibroblast-10 Cells;背景说明:详见相关文献介绍;传代方法:1:2-1:3传代;每周换液2-3次。;生长特性:贴壁或悬浮,详见产品说明书部分;形态特性:详见产品说明书;相关产品有:58F细胞、PNT1A细胞、JVM-2细胞
HS766T Cells;背景说明:详见相关文献介绍;传代方法:1:2—1:8传代,每周换液2—3次;生长特性:贴壁生长;形态特性:上皮细胞;相关产品有:CTLL(2)细胞、HMO6细胞、PZ-HPV-7细胞
NCI-H157 Cells;背景说明:详见相关文献介绍;传代方法:1:2传代;生长特性:贴壁生长 ;形态特性:详见产品说明书;相关产品有:Tu 212细胞、SUD4细胞、CAL 12T细胞
NCI-H157 Cells;背景说明:详见相关文献介绍;传代方法:1:2传代;生长特性:贴壁生长 ;形态特性:详见产品说明书;相关产品有:Tu 212细胞、SUD4细胞、CAL 12T细胞
MES 23.5 Cells;背景说明:多巴胺能神经元 Cells;传代方法:1:2-1:3传代;每周换液2-3次。;生长特性:贴壁;形态特性:详见产品说明书;相关产品有:C2A细胞、Mono Mac6细胞、P3/ag细胞
HPASMC Cells;背景说明:肺动脉平滑肌 Cells;传代方法:1:2-1:3传代;每周换液2-3次。;生长特性:贴壁;形态特性:详见产品说明书;相关产品有:SW780细胞、Hs-600-T细胞、PAMC82细胞
Epstein-Barr-1 Cells;背景说明:详见相关文献介绍;传代方法:1:2传代;生长特性:悬浮生长 ;形态特性:淋巴母细胞样;相关产品有:HIT T-15细胞、HCC1359细胞、MDCC-MSB-1细胞
VM-CUB-I Cells;背景说明:详见相关文献介绍;传代方法:1:2-1:3传代;每周换液2-3次。;生长特性:贴壁或悬浮,详见产品说明书部分;形态特性:详见产品说明书;相关产品有:SHIN-3细胞、HFL 1细胞、HOS(TE85)细胞
N87 Cells;背景说明:NCI-N87细胞表达表面糖蛋白癌胚抗原(CEA)和TAG72,并且没有左旋多巴胺脱羧酶(DDC)活性。它们的血管活性的肠肽(VIP)受体活性极低并缺乏胃泌激素受体。它们表达蕈毒碱胆碱受体。没有证据表明存在N-myc,L-myc,myb和EGF受体基因的重组。这个细胞株表达的c-myc和c-erb-B2RNA水平与其它细胞株相当。以下基因不表达:N-myc,L-myc,c-cis,IGF-2,或胃泌激素释放肽。报道NCI-N87细胞的植板率为4.3%。;传代方法:消化15-20分钟。1:2。4-5天长满。;生长特性:贴壁生长;形态特性:上皮细胞样;相关产品有:HDSMC细胞、Th17细胞、L-M(TK-)细胞
ID8 Cells;背景说明:详见相关文献介绍;传代方法:1:2传代;生长特性:贴壁生长 ;形态特性:详见产品说明书;相关产品有:IPI-2I细胞、RA 1细胞、FHs 74 Int细胞
SU86-86 Cells;背景说明:详见相关文献介绍;传代方法:1:2传代;;生长特性:贴壁生长;形态特性:详见产品说明书;相关产品有:H-4细胞、S3 HeLa细胞、UPCI:SCC090细胞
H87 Cells;背景说明:NCI-N87细胞表达表面糖蛋白癌胚抗原(CEA)和TAG72,并且没有左旋多巴胺脱羧酶(DDC)活性。它们的血管活性的肠肽(VIP)受体活性极低并缺乏胃泌激素受体。它们表达蕈毒碱胆碱受体。没有证据表明存在N-myc,L-myc,myb和EGF受体基因的重组。这个细胞株表达的c-myc和c-erb-B2RNA水平与其它细胞株相当。以下基因不表达:N-myc,L-myc,c-cis,IGF-2,或胃泌激素释放肽。报道NCI-N87细胞的植板率为4.3%。;传代方法:消化15-20分钟。1:2。4-5天长满。;生长特性:贴壁生长;形态特性:上皮细胞样;相关产品有:LNCaP-ATCC细胞、HEK293F细胞、RC-2细胞
┈订┈购(技术服务)┈热┈线:1┈3┈6┈4┈1┈9┈3┈0┈7┈9┈1【微信同号】┈Q┈Q:3┈1┈8┈0┈8┈0┈7┈3┈2┈4;
SRA01/04 (HLE) Cells;背景说明:晶状体;上皮细胞;SV40转化;男性;传代方法:1:2-1:3传代;每周换液2-3次。;生长特性:贴壁;形态特性:详见产品说明书;相关产品有:AMO-1细胞、SBC3细胞、3-LL细胞
KGN Cells;背景说明:该细胞株是颗粒细胞瘤。细胞在加入人体绒膜促性腺激素后可能产生孕酮。细胞生长缓慢。;传代方法:1:2-1:3传代;每周换液2-3次。;生长特性:贴壁;形态特性:上皮细胞样;相关产品有:SO-RB50细胞、HS688AT细胞、SKCO1细胞
CHO Cells;背景说明:1957年,PuckTT从成年中国仓鼠卵巢的活检组织建立了CHO细胞;广泛用于生物制品的表达。;传代方法:1:3传代,3-4天换液一次;生长特性:贴壁生长;形态特性:上皮样;相关产品有:MT-2细胞、EVSAT细胞、HECCL-1细胞
NRK49F Cells;背景说明:肾;成纤维细胞;自发永生;传代方法:1:2-1:3传代;每周换液2-3次。;生长特性:贴壁;形态特性:详见产品说明书;相关产品有:SN4741细胞、GM04678细胞、3T3-L1 ad细胞
OV1063 Cells;背景说明:卵巢上皮细胞癌;传代方法:1:2-1:3传代;每周换液2-3次。;生长特性:贴壁;形态特性:详见产品说明书;相关产品有:KYSE-30细胞、Colon38细胞、KMS-18细胞
CCRF.CEM Cells人急性淋巴细胞白血病T淋巴可传代细胞系(送STR鉴定图谱)
NCIH2227 Cells;背景说明:详见相关文献介绍;传代方法:1:2-1:4传代;每周换液2次。;生长特性:该细胞既有悬浮生长,又有贴壁生长;形态特性:上皮细胞;相关产品有:OK细胞、RCC-JF细胞、HMrSV5细胞
SW 837 Cells;背景说明:详见相关文献介绍;传代方法:1:2—1:5传代,每周换液1-2次;生长特性:悬浮生长;形态特性:上皮细胞;相关产品有:NCIH2122细胞、NCM-460细胞、Kasumi-1细胞
NCM-460 Cells;背景说明:详见相关文献介绍;传代方法:1:2传代;生长特性:贴壁生长;形态特性:详见产品说明书;相关产品有:H-2227细胞、H-220细胞、Roswell Park Memorial Institute 8226细胞
LAD 2 Cells;背景说明:肥大 Cells;传代方法:1:2-1:3传代;每周换液2-3次。;生长特性:悬浮;形态特性:详见产品说明书;相关产品有:GC-1细胞、SN4741细胞、Hs 746T细胞
MSC Cells;背景说明:详见相关文献介绍;传代方法:1:2-1:3传代;每周换液2-3次。;生长特性:贴壁或悬浮,详见产品说明书部分;形态特性:详见产品说明书;相关产品有:CALU1细胞、GT38细胞、ARPE-19细胞
H3396 Cells;背景说明:乳腺癌;传代方法:1:2-1:3传代;每周换液2-3次。;生长特性:贴壁;形态特性:详见产品说明书;相关产品有:NCI-H1693细胞、KYSE 410细胞、WSU-DLCL(2)细胞
CMT167 Cells;背景说明:肺腺癌;雌性;C57BL/ICRF-a(t);传代方法:1:2-1:3传代;每周换液2-3次。;生长特性:贴壁;形态特性:详见产品说明书;相关产品有:NS1/1-Ag4.1细胞、LIM-1215细胞、MC/CAR细胞
Ubigene A-549 DGKQ KO Cells(提供STR鉴定图谱)
UOMi010-A Cells(提供STR鉴定图谱)
2D6F9 Cells(提供STR鉴定图谱)
NIH3T3 Cells;背景说明:详见相关文献介绍;传代方法:1:2-1:3传代;每周换液2-3次。;生长特性:贴壁或悬浮,详见产品说明书部分;形态特性:详见产品说明书;相关产品有:MGH-U1细胞、266 Bl细胞、TE-4细胞
L428 Cells;背景说明:霍奇金淋巴瘤;女性;传代方法:1:2-1:3传代;每周换液2-3次。;生长特性:悬浮;形态特性:详见产品说明书;相关产品有:Roswell Park Memorial Institute 2650细胞、MCF-7/AdrR细胞、H82细胞
HC-11 Cells;背景说明:详见相关文献介绍;传代方法:1:2-1:3传代;每周换液2-3次。;生长特性:贴壁或悬浮,详见产品说明书部分;形态特性:详见产品说明书;相关产品有:Hca-F细胞、BT-483细胞、KATO 3细胞
Ect1/E6E7 Cells;背景说明:宫颈;女性;HPV-16转化;传代方法:1:2-1:3传代;每周换液2-3次。;生长特性:贴壁;形态特性:详见产品说明书;相关产品有:NIH-3T3-L1细胞、H-676B细胞、End1/E6E7细胞
CMT167 Cells;背景说明:肺腺癌;雌性;C57BL/ICRF-a(t);传代方法:1:2-1:3传代;每周换液2-3次。;生长特性:贴壁;形态特性:详见产品说明书;相关产品有:NS1/1-Ag4.1细胞、LIM-1215细胞、MC/CAR细胞
H1770 Cells;背景说明:详见相关文献介绍;传代方法:随细胞的生长而换液;生长特性:悬浮生长;形态特性:详见产品说明书;相关产品有:H-209细胞、HuH1细胞、Ku812细胞
U937 Cells;背景说明:该细胞是由NilssonK实验室于1974年从一名37岁的患有恶性组织细胞性淋巴瘤的白人男性的胸水中分离建立的。1979年来的研究显示该细胞在人混合淋巴细胞培养物上清、佛波酯、VitD3、γ-IFN、TNF和维A酸的诱导下可以向终末单核细胞分化。该细胞不合成免疫球蛋白,EBV阴性;可产生溶菌酶、β-2-微球蛋白,受PMA刺激后可产生TNF-α;表达C3R;可作转染宿主;表达Fas,对TNF和抗Fas的抗体敏感。;传代方法:维持细胞浓度在1×105-2×106/ml;根据细胞浓度3-4换液1次。;生长特性:悬浮生长;形态特性:单核细胞;相关产品有:Kasumi-6细胞、Rat Lung-65细胞、SF 126细胞
SNU398 Cells;背景说明:详见相关文献介绍;传代方法:1:2传代;生长特性:贴壁生长;形态特性:上皮样;相关产品有:G 401细胞、SKUT-1细胞、SK-N-BE(2)-C细胞
PASMCS Cells;背景说明:肺动脉平滑肌 Cells;传代方法:1:2-1:3传代;每周换液2-3次。;生长特性:贴壁;形态特性:详见产品说明书;相关产品有:138MG细胞、P3 88 D1细胞、DLD1细胞
SK-RC-39 Cells;背景说明:详见相关文献介绍;传代方法:1:2-1:3传代;每周换液2-3次。;生长特性:贴壁或悬浮,详见产品说明书部分;形态特性:详见产品说明书;相关产品有:PE/CA-PJ34细胞、BT.549细胞、COR-L51细胞
LN299 Cells;背景说明:胶质瘤;传代方法:1:2-1:3传代;每周换液2-3次。;生长特性:贴壁;形态特性:详见产品说明书;相关产品有:Rat1细胞、ROS 17/28细胞、EB-1细胞
RAT2 Cells;背景说明:成纤维细胞;自发永生;Fischer 344;传代方法:1:2-1:3传代;每周换液2-3次。;生长特性:贴壁;形态特性:详见产品说明书;相关产品有:Rat 2细胞、Walker256细胞、P31 FUJ细胞
HT 1197.T Cells;背景说明:详见相关文献介绍;传代方法:1:5-1:10传代,2天换液1次。;生长特性:贴壁生长;形态特性:详见产品说明书;相关产品有:RBSMC细胞、RMS 13细胞、KNS-42细胞
CZ-1 Cells;背景说明:骨髓瘤;男性;传代方法:1:2-1:3传代;每周换液2-3次。;生长特性:悬浮;形态特性:详见产品说明书;相关产品有:ST细胞、EFO-27细胞、HMC细胞
HARAB Cells;背景说明:详见相关文献介绍;传代方法:1:2-1:3传代;每周换液2-3次。;生长特性:贴壁或悬浮,详见产品说明书部分;形态特性:详见产品说明书;相关产品有:EA. hy 926细胞、Jurkat FHCRC细胞、FUOV1细胞
Kupffer Cells;背景说明:详见相关文献介绍;传代方法:1:2-1:3传代;每周换液2-3次。;生长特性:贴壁;形态特性:详见产品说明书;相关产品有:Hs-729-T细胞、HN 4细胞、SUM 190PT细胞
HLEB3 Cells;背景说明:晶状体;Ad12-SV40转化;男性;传代方法:1:2-1:3传代;每周换液2-3次。;生长特性:贴壁;形态特性:详见产品说明书;相关产品有:McA-RH 7777细胞、2780CP细胞、NRK-52E细胞
Jurkat-FHCRC Cells;背景说明:该细胞源自一位14岁患有T淋巴细胞白血病男性的外周血;传代方法:保持细胞密度在3—9×105cells/ml之间,1:5—1:10传代,每周换液2—3次;生长特性:悬浮生长;形态特性:圆形,单个或呈片;相关产品有:SNK-1细胞、SKLMS1细胞、H-508细胞
SK-N-BE(2C) Cells;背景说明:神经母细胞瘤;骨髓转移;男性;传代方法:1:2-1:3传代;每周换液2-3次。;生长特性:贴壁;形态特性:详见产品说明书;相关产品有:MOLP8细胞、INS1E细胞、LM2-4175细胞
SK-N-BE(2C) Cells;背景说明:神经母细胞瘤;骨髓转移;男性;传代方法:1:2-1:3传代;每周换液2-3次。;生长特性:贴壁;形态特性:详见产品说明书;相关产品有:MOLP8细胞、INS1E细胞、LM2-4175细胞
3T3(A31) Cells;背景说明:胚胎;成纤维;自发永生;雄性;BALB/c;传代方法:1:2-1:3传代;每周换液2-3次。;生长特性:贴壁;形态特性:详见产品说明书;相关产品有:MKN-1细胞、H-548细胞、PL-11细胞
CAOV3 Cells;背景说明:该细胞1976年建系,源自一位54岁白人女性的卵巢腺癌组织。;传代方法:1:3传代,2—3天换液一次;生长特性:贴壁生长;形态特性:上皮样;相关产品有:CEL细胞、ACHN细胞、B16-F1细胞
HEK293-A Cells;背景说明:胚肾;腺病毒包装;传代方法:1:2-1:3传代;每周换液2-3次。;生长特性:贴壁;形态特性:详见产品说明书;相关产品有:UPCI:SCC154细胞、H-2170细胞、C-4-I细胞
SKMEL-1 Cells;背景说明:详见相关文献介绍;传代方法:维持细胞浓度在1×105-2×105,每周补液2-3次。;生长特性:悬浮生长;形态特性:球形的;相关产品有:Walker256细胞、ST 486细胞、MC3T3-E1细胞
Mhh-Call 2 Cells;背景说明:急性B淋巴细胞白血病;女性;传代方法:1:2-1:3传代;每周换液2-3次。;生长特性:悬浮;形态特性:详见产品说明书;相关产品有:GP2-293细胞、RBVEC细胞、J 774A.1细胞
HEK/293 Cells;背景说明:详见相关文献介绍;传代方法:1:2-1:3传代;每周换液2-3次。;生长特性:贴壁或悬浮,详见产品说明书部分;形态特性:详见产品说明书;相关产品有:VMM5A细胞、Human Corneal Epithelial cells-Transformed细胞、L-M[TK-]细胞
H1734 Cells;背景说明:详见相关文献介绍;传代方法:1:4-1:6传代。;生长特性:贴壁生长;形态特性:上皮细胞样;相关产品有:H-250细胞、211H细胞、BE2C细胞
NCI H929 Cells;背景说明:详见相关文献介绍;传代方法:保持细胞密度在5×105—1×106 cells/ml之间,每周换液2—3次;生长特性:悬浮生长 ;形态特性:淋巴母细胞样;相关产品有:SUM 159细胞、J82COT细胞、CCRF-CEM细胞
┈订┈购(技术服务)┈热┈线:1┈3┈6┈4┈1┈9┈3┈0┈7┈9┈1【微信同号】┈Q┈Q:3┈1┈8┈0┈8┈0┈7┈3┈2┈4;
Hs-281-T Cells;背景说明:详见相关文献介绍;传代方法:1:2传代,每周换液2-3次。;生长特性:贴壁生长;形态特性:成纤维细胞;相关产品有:NPC-TW01细胞、OVCA432_Bast细胞、HT 1080细胞
NCI-H2107 Cells;背景说明:详见相关文献介绍;传代方法:3-4天换液1次。;生长特性:悬浮生长 ;形态特性:上皮细胞;相关产品有:MCF-7/ADR-RES细胞、COLO206F细胞、K422细胞
NCI-H711 Cells;背景说明:详见相关文献介绍;传代方法:1:2-1:3传代;每周换液2-3次。;生长特性:贴壁或悬浮,详见产品说明书部分;形态特性:详见产品说明书;相关产品有:P3/X63/Ag8细胞、BEL-7405细胞、EoL-1-cell细胞
MZCRC1 Cells;背景说明:甲状腺髓样癌;女性;传代方法:1:2-1:3传代;每周换液2-3次。;生长特性:贴壁;形态特性:详见产品说明书;相关产品有:PNT-1A细胞、YD15细胞、HLF-a细胞
Gingival carcinoma Neck Metastasis Cells;背景说明:详见相关文献介绍;传代方法:1:2-1:3传代;每周换液2-3次。;生长特性:贴壁或悬浮,详见产品说明书部分;形态特性:详见产品说明书;相关产品有:NIH/3T3细胞、BV-173细胞、HEK/293细胞
MCF7 Cells;背景说明:MCF-7细胞保留了多个分化了的乳腺上皮的特性,包括:能通过胞质雌激素受体加工雌二醇并能形成圆形复合物(domes)。该细胞含有Tx-4癌基因。肿瘤坏死因子α(TNFalpha)可以抑制MCF-7细胞的生长。抗雌激素处理细胞能调变IGFBP'S的分泌。;传代方法:1:2传代,3-4天长满;生长特性:贴壁生长;形态特性:上皮样;相关产品有:CHG5细胞、Tb1.Lu细胞、H1694细胞
OCI-AML-4 Cells;背景说明:急性髓系白血病;女性;传代方法:1:2-1:3传代;每周换液2-3次。;生长特性:悬浮;形态特性:详见产品说明书;相关产品有:SK-N-DZ细胞、RPMI-6666细胞、HEM-L细胞
HN4 Cells;背景说明:喉鳞癌;男性;传代方法:1:2-1:3传代;每周换液2-3次。;生长特性:贴壁;形态特性:详见产品说明书;相关产品有:LA4细胞、OAW-42细胞、OKT 3细胞
MPC11 Cells;背景说明:详见相关文献介绍;传代方法:1:2传代;生长特性:悬浮生长;形态特性:详见产品说明书;相关产品有:KNS-62细胞、CX-1细胞、SNU-C2B细胞
UMC11 Cells;背景说明:肺肿瘤;男性;传代方法:1:2-1:3传代;每周换液2-3次。;生长特性:贴壁;形态特性:详见产品说明书;相关产品有:OVCA-420细胞、H1092细胞、SUDHL-8细胞
CCRF.CEM Cells人急性淋巴细胞白血病T淋巴可传代细胞系(送STR鉴定图谱)
BayGenomics ES cell line CSJ286 Cells(提供STR鉴定图谱)
BayGenomics ES cell line TEA124 Cells(提供STR鉴定图谱)
CCRC-M25 Cells(提供STR鉴定图谱)
M4 [Mouse hybridoma against human CKLF] Cells(提供STR鉴定图谱)
RMab-22 Cells(提供STR鉴定图谱)
SMG-C6 Cells(提供STR鉴定图谱)
"